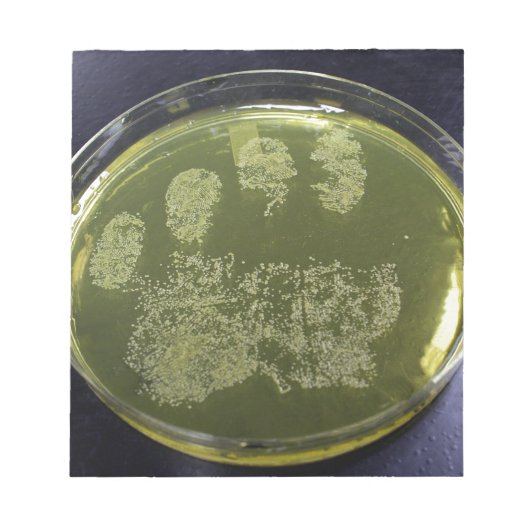

A propos de Blocs-notes
Vendu (e) par
À propos de ce design
Bloc-note Bactéries à plat Petri à main
Une photo de Staphylococcus aureus poussant sur une assiette de gélose au sel de mannitol.
Traduction automatique
Avis des clients
5.0 sur 5 étoiles1 Nombres de Commentaires
1 Commentaires
Avis sur des produits similaires
5 sur 5 étoiles
Par Sandrine P.2 mai 2022 • Achat sécurisé
Blocs-notes 14cmx15.2cm - 40 pages
Programme d'évaluation de Zazzle
propre & classe, fait tres pro. correspond à l image, brillant & classe
Tags
Autres infos
Identifiant du produit : 133442291875458341
Fabriqué le 24/12/2013 9:11
Évalué G
Articles vus récemment